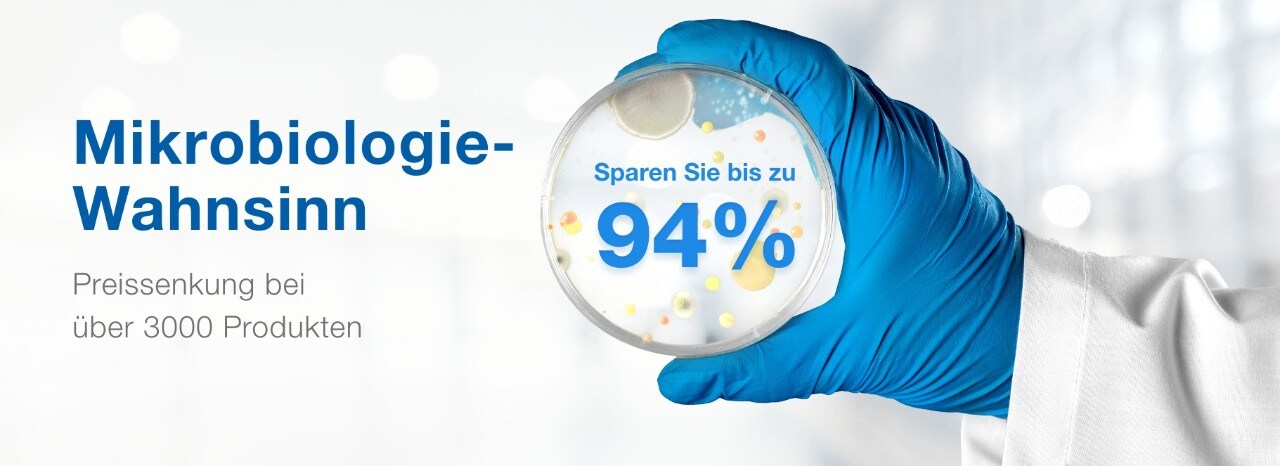
24118_Mega_Microbiology_banner_page_desktop_DE 24118_Mega_Microbiology_banner_page_desktop_DE

Mikrobiologie-Wahnsinn
Entdecken Sie unser umfangreiches Mikrobiologie-Portfolio mit Preisvorteilen bei über 3000 Produkten für die Probenvorbereitung, Chemikalien, Reagenzien, Verbrauchsmaterialien und Geräte.
Verwenden Sie den Promo-Code 24118* um Ihre exklusiven Ersparnisse freizuschalten.
Finden Sie Ihre Produkte in den untenstehenden Kategorien.
- Kühllagerung
Ausrüstung und Geräte
- Konstante Temperatur
- Pumpen
Laborgeräte
- Laborzubehör
Laborverbrauchsmaterialien
- Cellomics
- Klinische Verbrauchsmaterialien
- Genomik
- Life Science-Instrumente
- Mikrobiologie